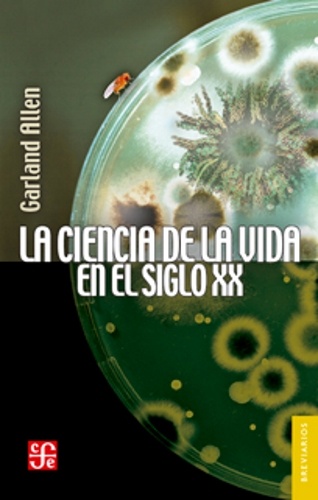
La ciencia de la vida en el siglo XX

Garland Allen
La ciencia de la vida en el siglo XX
$18.900
$21.000
PREVENTA
Peso: 400 g
ISBN: 9786071656735
Editorial: Fondo de Cultura Economica
CANTIDAD
-
+
Agregar al carrito